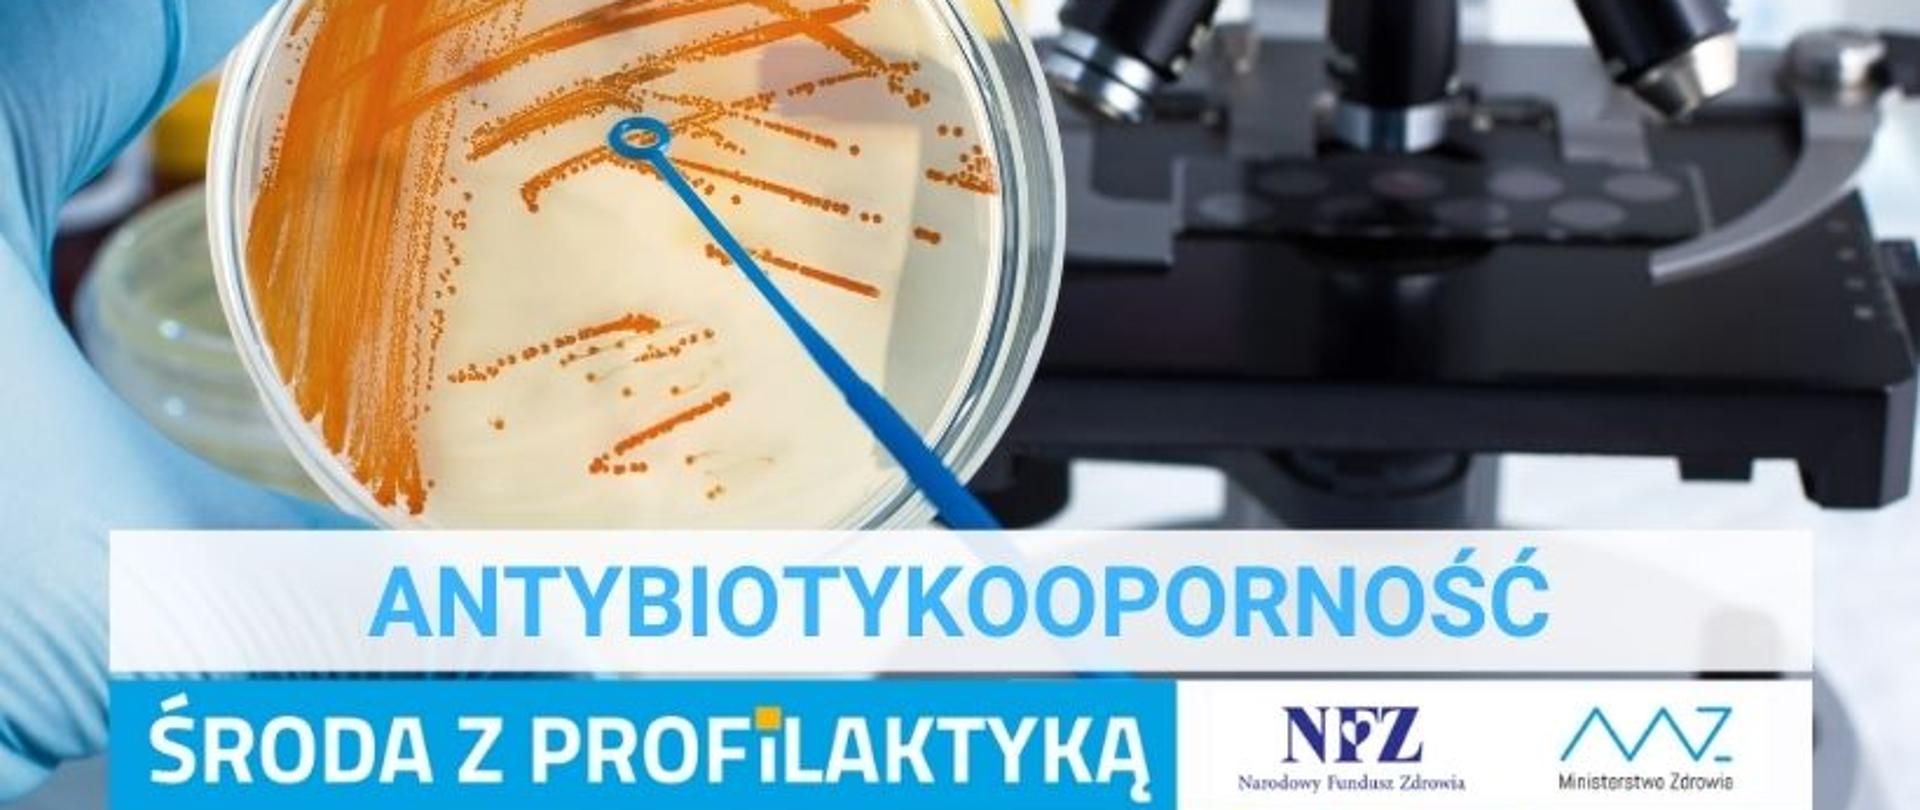
Środa z profilaktyką- Antybiotykooporność

Środa z profilaktyką- Antybiotykooporność
16.02.2022
Antybiotykooporność to zdolność bakterii do przeciwstawiania się działaniu antybiotyków. WHO szacuje, że oporność mikroorganizmów na leki przyczynia się rocznie do 75 tys. zgonów. Dla Polski liczbę takich przypadków określono na ok. 2 200 rocznie.
Materiały
Ulotka- Środa z profilaktyką- AntybiotykoopornośćUlotkaff.pdf 0.72MB